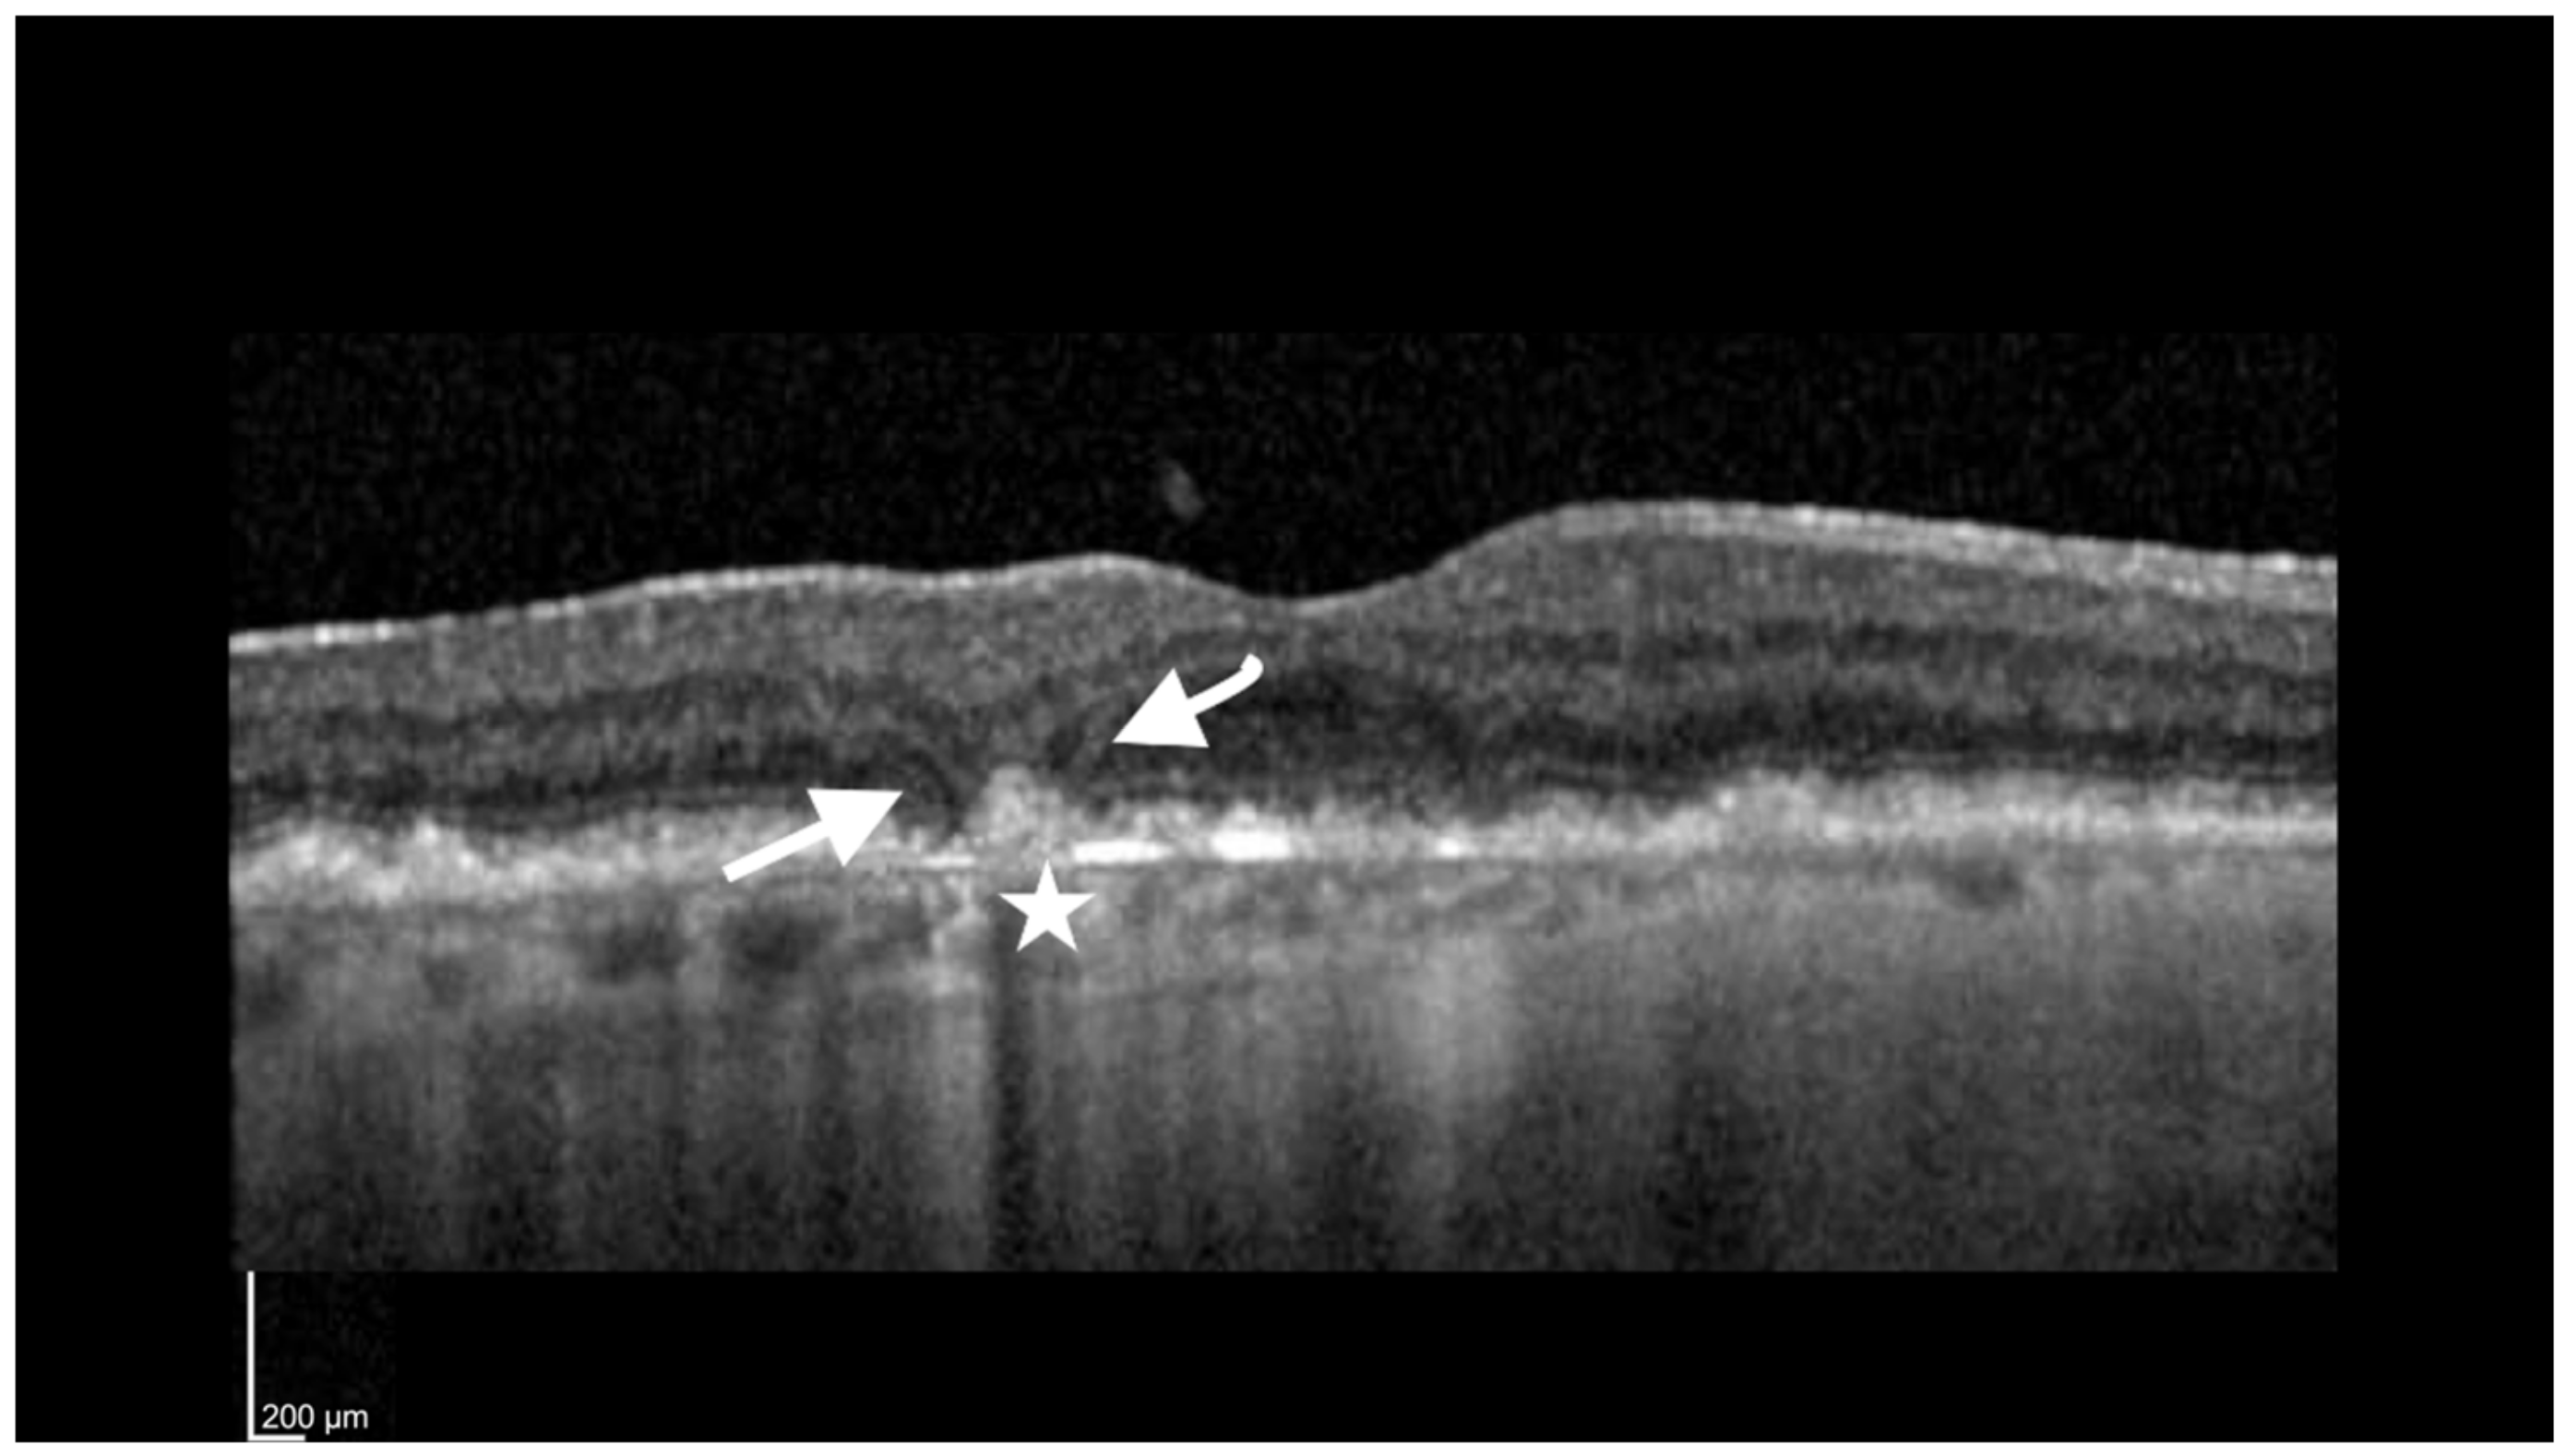
Jcm 12 05131 g002 Jcm 12 05131 g002

Complement Inhibitors for Advanced Dry Age-Related Macular Degeneration (Geographic Atrophy): Some Light at the End of the Tunnel?
Abstract
1. Introduction
2. Pegcetacoplan (Sifovre)
3. Avacincaptad Pegol (Zimura)
4. Conclusions and Future Directions
Supplementary Materials
Funding
Institutional Review Board Statement
Informed Consent Statement
Data Availability Statement
Conflicts of Interest
References
- Wong, W.L.; Su, X.; Li, X.; Cheung, C.M.G.; Klein, R.; Cheng, C.Y.; Wong, T.Y. Global prevalence of age-related macular degeneration and disease burden projection for 2020 and 2040: A systematic review and meta-analysis. Lancet Glob. Health 2014, 2, e106–e116. [Google Scholar] [CrossRef]
- Haines, J.L.; Hauser, M.A.; Schmidt, S.; Scott, W.K.; Olson, L.M.; Gallins, P.; Spencer, K.L.; Kwan, S.Y.; Noureddine, M.; Gilbert, J.R.; et al. Complement Factor H Variant Increases the Risk of Age-Related Macular Degeneration. Science 2005, 308, 419–421. [Google Scholar] [CrossRef]
- Rudnicka, A.R.; Jarrar, Z.; Wormald, R.; Cook, D.G.; Fletcher, A.; Owen, C.G. Age and gender variations in age-related macular degeneration prevalence in populations of European ancestry: A meta-analysis. Ophthalmology 2012, 119, 571–580. [Google Scholar] [CrossRef] [PubMed]
- Boyer, D.S.; Schmidt-Erfurth, U.; van Lookeren Campagne, M.; Henry, E.C.; Brittain, C. The pathophysiology of geographic atrophy secondary to age-related macular degeneration and the complement pathway as a therapeutic target. Retina 2017, 37, 819–835. [Google Scholar] [CrossRef] [PubMed]
- Holz, F.G.; Strauss, E.C.; Schmitz-Valckenberg, S.; van Lookeren Campagne, M. Geographic atrophy: Clinical features and potential therapeutic approaches. Ophthalmology 2014, 121, 1079–1091. [Google Scholar] [CrossRef] [PubMed]
- Schmitz-Valckenberg, S.; Sadda, S.; Staurenghi, G.; Chew, E.Y.; Fleckenstein, M.; Holz, F.G. Geographic atrophy: Semantic Considerations and Literature Review. Retina 2016, 36, 2250–2264. [Google Scholar] [CrossRef]
- Guymer, R.H.; Rosenfeld, P.J.; Curcio, C.A.; Holz, F.G.; Staurenghi, G.; Freund, K.B.; Schmitz-Valckenberg, S.; Sparrow, J.; Spaide, R.F.; Tufail, A.; et al. Incomplete Retinal Pigment Epithelial and Outer Retinal Atrophy in Age-Related Macular Degeneration: Classification of Atrophy Meeting Report 4. Ophthalmology 2020, 127, 394–409. [Google Scholar] [CrossRef] [PubMed]
- Freeman, W.R.; Bandello, F.; Souied, E.; Guymer, R.H.; Garg, S.J.; Chen, F.K.; Rich, R.; Holz, F.G.; Patel, S.S.; Kim, K.; et al. Randomized Phase IIb Study of Brimonidine Drug Delivery System Generation 2 for Geographic Atrophy in Age-Related Macular Degeneration. Ophthalmol. Retin. 2023, 7, 573–585. [Google Scholar] [CrossRef]
- Zhang, K.; Hopkins, J.J.; Heier, J.S.; Birch, D.G.; Halperin, L.S.; Albini, T.A.; Brown, D.M.; Jaffe, G.J.; Tao, W.; Williams, G.A. Ciliary neurotrophic factor delivered by encapsulated cell intraocular implants for treatment of geographic atrophy in age-related macular degeneration. Proc. Natl. Acad. Sci. USA 2011, 108, 6241–6245. [Google Scholar] [CrossRef]
- Rosenfeld, P.J.; Berger, B.; Reichel, E.; Danis, R.P.; Gress, A.; Ye, L.; Magee, M.; Parham, L.R.; McLaughlin, M.M. A Randomized Phase 2 Study of an Anti-Amyloid beta Monoclonal Antibody in Geographic Atrophy Secondary to Age-Related Macular Degeneration. Ophthalmol. Retin. 2018, 2, 1028–1040. [Google Scholar] [CrossRef]
- Yeong, J.L.; Loveman, E.; Colquitt, J.L.; Royle, P.; Waugh, N.; Lois, N. Visual cycle modulators versus placebo or observation for the prevention and treatment of geographic atrophy due to age-related macular degeneration. Cochrane Database Syst. Rev. 2020, 12, CD013154. [Google Scholar] [CrossRef] [PubMed][Green Version]
- Klein, R.J.; Zeiss, C.; Chew, E.Y.; Tsai, J.-Y.; Sackler, R.S.; Haynes, C.; Henning, A.K.; SanGiovanni, J.P.; Mane, S.M.; Mayne, S.T.; et al. Complement Factor H Polymorphism in Age-Related Macular Degeneration. Science 2005, 308, 385–389. [Google Scholar] [CrossRef] [PubMed]
- Edwards, A.O.; Ritter, R., 3rd; Abel, K.J.; Manning, A.; Panhuysen, C.; Farrer, L.A. Complement factor H polymorphism and age-related macular degeneration. Science 2005, 308, 421–424. [Google Scholar] [CrossRef] [PubMed]
- Hageman, G.S.; Anderson, D.H.; Johnson, L.V.; Hancox, L.S.; Taiber, A.J.; Hardisty, L.I.; Hageman, J.L.; Stockman, H.A.; Borchardt, J.D.; Gehrs, K.M.; et al. A common haplotype in the complement regulatory gene factor H (HF1/CFH) predisposes individuals to age-related macular degeneration. Proc. Natl. Acad. Sci. USA 2005, 102, 7227–7232. [Google Scholar] [CrossRef]
- The AMD Gene Consortium. Seven new loci associated with age-related macular degeneration. Nat Genet. 2013, 45, 433–439. [Google Scholar] [CrossRef]
- Anderson, D.H.; Radeke, M.J.; Gallo, N.B.; Chapin, E.A.; Johnson, P.T.; Curletti, C.R.; Hancox, L.S.; Hu, J.; Ebright, J.N.; Malek, G.; et al. The pivotal role of the complement system in aging and age-related macular degeneration: Hypothesis re-visited. Prog. Retin. Eye Res. 2010, 29, 95–112. [Google Scholar] [CrossRef]
- Walport, M.J. Complement. First of two parts. N. Engl. J. Med. 2001, 344, 1058–1066. [Google Scholar] [CrossRef]
- De Castro, C.; Grossi, F.; Weitz, I.C.; Maciejewski, J.; Sharma, V.; Roman, E.; Brodsky, R.A.; Tan, L.; Di Casoli, C.; El Mehdi, D.; et al. C3 inhibition with pegcetacoplan in subjects with paroxysmal nocturnal hemoglobinuria treated with eculizumab. Am. J. Hematol. 2020, 95, 1334–1343. [Google Scholar] [CrossRef]
- Walport, M.J. Complement. Second of two parts. N. Engl. J. Med. 2001, 344, 1140–1144. [Google Scholar] [CrossRef]
- Kim, B.J.; Mastellos, D.C.; Li, Y.; Dunaief, J.L.; Lambris, J.D. Targeting complement components C3 and C5 for the retina: Key concepts and lingering questions. Prog. Retin. Eye Res. 2021, 83, 100936. [Google Scholar] [CrossRef]
- Calippe, B.; Augustin, S.; Beguier, F.; Charles-Messance, H.; Poupel, L.; Conart, J.-B.; Hu, S.J.; Lavalette, S.; Fauvet, A.; Rayes, J.; et al. Complement Factor H Inhibits CD47-Mediated Resolution of Inflammation. Immunity 2017, 46, 261–272. [Google Scholar] [CrossRef] [PubMed]
- Broz, P.; Dixit, V.M. Inflammasomes: Mechanism of assembly, regulation and signalling. Nat. Rev. Immunol. 2016, 16, 407–420. [Google Scholar] [CrossRef]
- Al Shaer, D.; Al Musaimi, O.; Albericio, F.; de la Torre, B.G. 2021 FDA TIDES (Peptides and Oligonucleotides) Harvest. Pharmaceuticals 2022, 15, 222. [Google Scholar] [CrossRef] [PubMed]
- Liao, D.S.; Grossi, F.V.; El Mehdi, D.; Gerber, M.R.; Brown, D.M.; Heier, J.S.; Wykoff, C.C.; Singerman, L.J.; Abraham, P.; Grassmann, F.; et al. Complement C3 Inhibitor Pegcetacoplan for Geographic Atrophy Secondary to Age-Related Macular Degeneration: A Randomized Phase 2 Trial. Ophthalmology 2020, 127, 186–195. [Google Scholar] [CrossRef] [PubMed]
- The AREDS Research Group. Change in area of geographic atrophy in the Age-Related Eye Disease Study: AREDS report number 26. Arch Ophthalmol. 2009, 127, 1168–1174. [Google Scholar] [CrossRef]
- Feuer, W.J.; Yehoshua, Z.; Gregori, G.; Penha, F.M.; Chew, E.Y.; Ferris, F.L.; Clemons, T.E.; Lindblad, A.S.; Rosenfeld, P.J. Square Root Transformation of Geographic Atrophy Area Measurements to Eliminate Dependence of Growth Rates on Baseline Lesion Measurements: A Reanalysis of Age-Related Eye Disease Study Report No. 26. JAMA Ophthalmol. 2013, 131, 110–111. [Google Scholar] [CrossRef]
- Steinle, N.C.; Pearce, I.; Monés, J.; Metlapally, R.; Saroj, N.; Hamdani, M.; Ribeiro, R.; Rosenfeld, P.J.; Lad, E.M. Impact of Baseline Characteristics on Geographic Atrophy Progression in the FILLY Trial Evaluating the Complement C3 Inhibitor Pegcetacoplan. Am. J. Ophthalmol. 2021, 227, 116–124. [Google Scholar] [CrossRef]
- Riedl, S.; Vogl, W.-D.; Mai, J.; Reiter, G.S.; Lachinov, D.; Grechenig, C.; McKeown, A.; Scheibler, L.; Bogunović, H.; Schmidt-Erfurth, U. The Effect of Pegcetacoplan Treatment on Photoreceptor Maintenance in Geographic Atrophy Monitored by Artificial Intelligence–Based OCT Analysis. Ophthalmol. Retin. 2022, 6, 1009–1018. [Google Scholar] [CrossRef] [PubMed]
- Nittala, M.G.; Metlapally, R.; Ip, M.; Chakravarthy, U.; Holz, F.G.; Staurenghi, G.; Waheed, N.S.B.; Lindenberg, S.; Karamat, A. Association of Pegcetacoplan with Progression of Incomplete Retinal Pigment Epithelium and Outer Retinal Atrophy in Age-Related Macular Degeneration: A Post Hoc Analysis of the FILLY Randomized Clinical Trial. JAMA Ophthalmol. 2022, 140, 243–249. [Google Scholar] [CrossRef]
- Mai, J.; Riedl, S.; Reiter, G.S.; Lachinov, D.; Vogl, W.-D.; Bogunovic, H.; Schmidt-Erfurth, U. Comparison of Fundus Autofluorescence Versus Optical Coherence Tomography–based Evaluation of the Therapeutic Response to Pegcetacoplan in Geographic Atrophy. Am. J. Ophthalmol. 2022, 244, 175–182. [Google Scholar] [CrossRef]
- Vogl, W.D.; Riedl, S.; Mai, J.; Reiter, G.S.; Lachinov, D.; Bogunović, H.; Schmidt-Erfurth, U. Predicting Topographic Disease Progression and Treatment Response of Pegcetacoplan in Geographic Atrophy Quantified by Deep Learning. Ophthalmol. Retin. 2023, 7, 4–13. [Google Scholar] [CrossRef] [PubMed]
- Goldberg, R.; Heier, J.S.; Wykoff, C.C.; Staurenghi, G.; Singh, R.P.; Steinle, N. Efficacy of Intravitreal Pegcetacoplan in Patients with Geographic Atrophy (GA): 12-Month Results from the Phase 3 OAKS and DERBY studies. Investig. Ophthalmol. Vis. Sci. 2022, 63, 1500. [Google Scholar]
- Chiang, A.; Bliss, C.; Ribeiro, R. Assessment of Geographic Atrophy (GA) Lesion Progression in the Phase 3 OAKS and DERBY Trials. Investig. Ophthalmol. Vis. Sci. 2023, 64, 986. [Google Scholar]
- Wykoff, C.C.; Rosenfeld, P.J.; Waheed, N.K.; Singh, R.P.; Ronca, N.; Slakter, J.S.; Staurenghi, G.; Monés, J.; Baumal, C.R.; Saroj, N.; et al. Characterizing New-Onset Exudation in the Randomized Phase 2 FILLY Trial of Complement Inhibitor Pegcetacoplan for Geographic Atrophy. Ophthalmology 2021, 128, 1325–1336. [Google Scholar] [CrossRef]
- Sato, T.; Kishi, S.; Watanabe, G.; Matsumoto, H.; Mukai, R. Tomographic features of branching vascular networks in polypoidal choroidal vasculopathy. Retina 2007, 27, 589–594. [Google Scholar] [CrossRef]
- Shi, Y.; Motulsky, E.H.; Goldhardt, R.; Zohar, Y.; Thulliez, M.; Feuer, W.; Gregor, G.; Rosenfeld, P.J. Predictive Value of the OCT Double-Layer Sign for Identifying Subclinical Neovascularization in Age-Related Macular Degeneration. Ophthalmol. Retin. 2019, 3, 211–219. [Google Scholar] [CrossRef]
- Narita, C.; Wu, Z.; Rosenfeld, P.J.; Yang, J.; Lyu, C.; Caruso, E.; McGuinness, M.; Guymer, R.H. Structural OCT Signs Suggestive of Subclinical Nonexudative Macular Neovascularization in Eyes with Large Drusen. Ophthalmology 2020, 127, 637–647. [Google Scholar] [CrossRef]
- Yehoshua, Z.; de Amorim Garcia Filho, C.A.; Nunes, R.P.; Gregori, G.; Penha, F.M.; Moshfeghi, A.A.; Zhang, K.; Sadda, S.; Feuer, W.J.; Rosenfeld, P.J. Systemic complement inhibition with eculizumab for geographic atrophy in age-related macular degeneration: The COMPLETE study. Ophthalmology 2014, 121, 693–701. [Google Scholar] [CrossRef]
- Jaffe, G.J.; Westby, K.; Csaky, K.G.; Monés, J.; Pearlman, J.A.; Patel, S.S.; Joondeph, B.C.; Randolph, J.; Masonson, H.; Rezaei, K.A. C5 Inhibitor Avacincaptad Pegol for Geographic Atrophy Due to Age-Related Macular Degeneration: A Randomized Pivotal Phase 2/3 Trial. Ophthalmology 2021, 128, 576–586. [Google Scholar] [CrossRef]
- Patel, S.S.; Lally, D.R.; Hsu, J.; Wykoff, C.C.; Eichenbaum, D.; Heier, J.S.; Jaffe, G.J.; Westby, K.; Desai, D.; Zhu, L.; et al. Avacincaptad pegol for geographic atrophy secondary to age-related macular degeneration: 18-month findings from the GATHER1 trial. Eye 2023. [Google Scholar] [CrossRef]
- Khanani, A.M.; Patel, S.S.; Staurenghi, G. The Efficacy of Avacincaptad Pegol in Geographic Atrophy: GATHER1 and GATHER2 Results. In Proceedings of the The Retina Society 55th Annual Scientific Meeting, Pasadena, CA, USA, 2–5 November 2022. [Google Scholar]
- Kaiser, P.K.; Khanani, A.M.; Eichenbaum, D.A. Safety of Intravitreal Avacincaptad Pegol in Geographic Atrophy: GATHER1 and GATHER2 Results. In Proceedings of the The Retina Society 55th Annual Scientific Meeting, Pasadena, CA, USA, 2–5 November 2022. [Google Scholar]
- Guymer, R.H. Treating Geographic Atrophy–Are We Ready? A Call to Image. Ophthalmol. Retin. 2023, 7, 1–3. [Google Scholar] [CrossRef] [PubMed]
- Giani, A.; Pellegrini, M.; Carini, E.; Deiro, A.P.; Bottoni, F.; Staurenghi, G. The Dark Atrophy with Indocyanine Green Angiography in Stargardt Disease. Investig. Ophthalmol. Vis. Sci. 2012, 53, 3999–4004. [Google Scholar] [CrossRef]
- Pellegrini, M.; Acquistapace, A.; Oldani, M.; Cereda, M.G.; Giani, A.; Cozzi, M.; Staurenghi, G. Dark Atrophy: An Optical Coherence Tomography Angiography Study. Ophthalmology 2016, 123, 1879–1886. [Google Scholar] [CrossRef]
- Fleckenstein, M.; Mitchell, P.; Freund, K.B.; Sadda, S.; Holz, F.G.; Brittain, C.; Henry, E.C.; Ferrara, D. The Progression of Geographic Atrophy Secondary to Age-Related Macular Degeneration. Ophthalmology 2018, 125, 369–390. [Google Scholar] [CrossRef] [PubMed]
- Holz, F.G.; Bindewald-Wittich, A.; Fleckenstein, M.; Dreyhaupt, J.; Scholl, H.P.; Schmitz-Valckenberg, S. Progression of Geographic Atrophy and Impact of Fundus Autofluorescence Patterns in Age-related Macular Degeneration. Am. J. Ophthalmol. 2007, 143, 463–472. [Google Scholar] [CrossRef] [PubMed]
- Marsiglia, M.; Boddu, S.; Bearelly, S.; Xu, L.; Breaux, B.E.; Freund, K.B.; Yannuzzi, L.A.; Smith, R.T. Association Between Geographic Atrophy Progression and Reticular Pseudodrusen in Eyes with Dry Age-Related Macular Degeneration. Investig. Ophthalmol. Vis. Sci. 2013, 54, 7362–7369. [Google Scholar] [CrossRef]
- Wu, Z.; Fletcher, E.L.; Kumar, H.; Greferath, U.; Guymer, R.H. Reticular pseudodrusen: A critical phenotype in age-related macular degeneration. Prog. Retin. Eye Res. 2022, 88, 101017. [Google Scholar] [CrossRef] [PubMed]
- Wu, L.; Monge, M.; Araya, A. Subretinal drusenoid deposits: An update. Taiwan J. Ophthalmol. 2022, 12, 138–146. [Google Scholar] [CrossRef]
- Schmitz-Valckenberg, S.; Sahel, J.-A.; Danis, R.; Fleckenstein, M.; Jaffe, G.J.; Wolf, S.; Pruente, C.; Holz, F.G. Natural History of Geographic Atrophy Progression Secondary to Age-Related Macular Degeneration (Geographic Atrophy Progression Study). Ophthalmology 2016, 123, 361–368. [Google Scholar] [CrossRef]
- Fleckenstein, M.; Schmitz-Valckenberg, S.; Adrion, C.; Visvalingam, S.; Göbel, A.P.; Mössner, A.; von Strachwitz, C.N.; Mackensen, F.; Pauleikhoff, D.; Wolf, S.; et al. Progression of Age-Related Geographic Atrophy: Role of the Fellow Eye. Investig. Ophthalmol. Vis. Sci. 2011, 52, 6552–6557. [Google Scholar] [CrossRef]
- Shi, Y.; Zhang, Q.; Zhou, H.; Wang, L.; Chu, Z.; Jiang, X.; Shen, M.; Thulliez, M.; Lyu, C.; Feuer, W.; et al. Correlations Between Choriocapillaris and Choroidal Measurements and the Growth of Geographic Atrophy Using Swept Source OCT Imaging. Am. J. Ophthalmol. 2021, 224, 321–331. [Google Scholar] [CrossRef] [PubMed]
- Nassisi, M.; Baghdasaryan, E.; Borrelli, E.; Ip, M.; Sadda, S.R. Choriocapillaris flow impairment surrounding geographic atrophy correlates with disease progression. PLoS ONE 2019, 14, e0212563. [Google Scholar] [CrossRef] [PubMed]
- Teo, K.Y.; Fujimoto, S.; Sadda, S.R.; Kokame, G.; Gomi, F.; Kim, J.E.; Cheng, M.F.S.; Corradetti, G.; Amornpetchsathaporn, A.; Chainakul, M.; et al. Geographic Atrophy Phenotypes in Subjects of Different Ethnicity: Asia-Pacific Ocular Imaging Society Work Group Report 3. Ophthalmol. Retin. 2023, 7, 593–604. [Google Scholar] [CrossRef]
- Edmonds, R.; Steffen, V.; Honigberg, L.A.; Chang, M.C. The Role of the Complement Pathway in Clinical Progression of Geographic Atrophy: Analysis of the Phase III Chroma and Spectri Trials. Ophthalmol. Sci. 2023, 3, 100301. [Google Scholar] [CrossRef] [PubMed]
- Keenan, T.D.L. Re: Jaffe et al.: C5 inhibitor avacincaptad pegol for geographic atrophy due to age-related macular degeneration: A randomized pivotal phase 2/3 trial (Ophthalmology 2021, 128, 576–586). Ophthalmology 2021, 128, e25–e26. [Google Scholar] [CrossRef] [PubMed]

Disclaimer/Publisher’s Note: The statements, opinions and data contained in all publications are solely those of the individual author(s) and contributor(s) and not of MDPI and/or the editor(s). MDPI and/or the editor(s) disclaim responsibility for any injury to people or property resulting from any ideas, methods, instructions or products referred to in the content. |
© 2023 by the authors. Licensee MDPI, Basel, Switzerland. This article is an open access article distributed under the terms and conditions of the Creative Commons Attribution (CC BY) license (https://creativecommons.org/licenses/by/4.0/).
Share and Cite
Cruz-Pimentel, M.; Wu, L. Complement Inhibitors for Advanced Dry Age-Related Macular Degeneration (Geographic Atrophy): Some Light at the End of the Tunnel? J. Clin. Med. 2023, 12, 5131. https://doi.org/10.3390/jcm12155131
Cruz-Pimentel M, Wu L. Complement Inhibitors for Advanced Dry Age-Related Macular Degeneration (Geographic Atrophy): Some Light at the End of the Tunnel? Journal of Clinical Medicine. 2023; 12(15):5131. https://doi.org/10.3390/jcm12155131
Chicago/Turabian StyleCruz-Pimentel, Miguel, and Lihteh Wu. 2023. "Complement Inhibitors for Advanced Dry Age-Related Macular Degeneration (Geographic Atrophy): Some Light at the End of the Tunnel?" Journal of Clinical Medicine 12, no. 15: 5131. https://doi.org/10.3390/jcm12155131
APA StyleCruz-Pimentel, M., & Wu, L. (2023). Complement Inhibitors for Advanced Dry Age-Related Macular Degeneration (Geographic Atrophy): Some Light at the End of the Tunnel? Journal of Clinical Medicine, 12(15), 5131. https://doi.org/10.3390/jcm12155131

